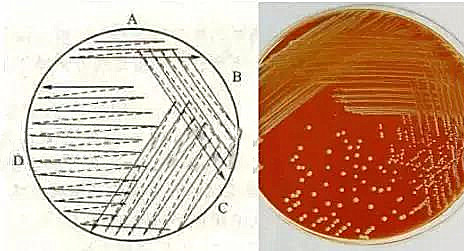
�DƬ

含有一種以上的微生物培養物稱為混和培養物。如果在一個菌落中所有細胞均來自于一個親代細胞,那么這個菌落稱為純培養。
分離純化是指,從混雜微生物群體中獲得只含有某一種或某一株微生物的過程。純種分離的目的是將目的菌從混雜的微生物中分離出來,獲得純培養。

分離純化的方法主要有以下幾種:
1、傾注平板法
首先把微生物懸液通過一系列稀釋,將稀釋后的樣品加入無菌培養基混合均勻。待凝固后倒置培養,單一細胞經過多次增殖后形成一個菌落,取單個菌落制成懸液,重復上述步驟數次,便可得到純培養物。

2、涂布平板法
涂布法接種是一種常用的接種方法,不僅可以用于計算活菌數,還可以利用其在平板表面生長形成菌苔的特點用于檢測化學因素對微生物的抑殺效應。
原理:將一定濃度,一定量的待分離菌液移到已凝固的培養基平板上,再用涂布棒快速地將其均勻涂布,使長出單菌落而達到分離的目的。

3、平板劃線法
最簡單的分離微生物的方法是平板劃線法。用無菌的接種環取培養物少許在平板上進行劃線。劃線的方法很多,常見的比較容易出現單個菌落的劃線方法有斜線法、曲線法、方格法、放射法、四格法等。

例如劃線法,將一個平板分成四個不同面積的小區進行劃線,第一區(A區)面積最小,作為待分離菌的菌源區,第二和第三區(B、C區)是逐級稀釋的過渡區,第四區(D區)則是關鍵區,使該區出現大量的單菌落以供挑選純種用。為了得到較多的典型單菌落,平板上四區面積的分配應是D>C>B>A。當接種環在培養基表面上往后移動時,接種環上的菌液逐漸稀釋,最后在所劃的線上分散著單個細胞,經培養,每一個細胞長成一個菌落。
4、富集培養法
指從微生物混合群開始,對特定種的數量比例不斷增高而引向純培養的一種培養方法。富集培養法的方法和原理非常簡單。我們可以創造一些條件只讓所需的微生物生長,在這些條件下,所需要的微生物能有效地與其他微生物進行競爭,在生長能力方面遠遠超過其他微生物。如果要分離一些專性寄生菌,就必須把樣品接種到相應敏感宿主細胞群體中,使其大量生長。通過多次重復移種便可以得到純的寄生菌。

5、厭氧法
在實驗室中,為了分離某些厭氧菌,可以利用裝有原培養基的試管作為培養容器,把這支試管放在沸水浴中加熱數分鐘,以便逐出培養基中的溶解氧。然后快速冷卻,并進行接種。接種后,加入無菌的石蠟于培養基表面,使培養基與空氣隔絕。

另一種方法是,在接種后,利用N2或CO2取代培養基中的氣體,然后在火焰上把試管口密封。有時為了更有效地分離某些厭氧菌,可以把所分離的樣品接種于培養基上,然后再把培養皿放在完全密封的厭氧培養裝置中。
6、單細胞分離法
單細胞分離法是一種從待分離的材料中直接分離單個細胞進行培養獲得純培養的方法。該法在顯微鏡下操作,對于體積較大的微生物,可以用毛細管提取微生物個體;對較小的細胞或孢子,可以用顯微針、鉤、環等挑取以獲得單細胞;也可將適當稀釋后的樣品制成小液滴,在顯微鏡下選取只含有一個細胞的液滴培養。

怎么樣?各種微生物的培養與分離的方法,你學會了嗎?在選擇純化培養時,我們需要根據微生物的特性從而選擇適宜培養的條件和環境。同時也要結合實驗的成本及條件。








當前所在頁面:















